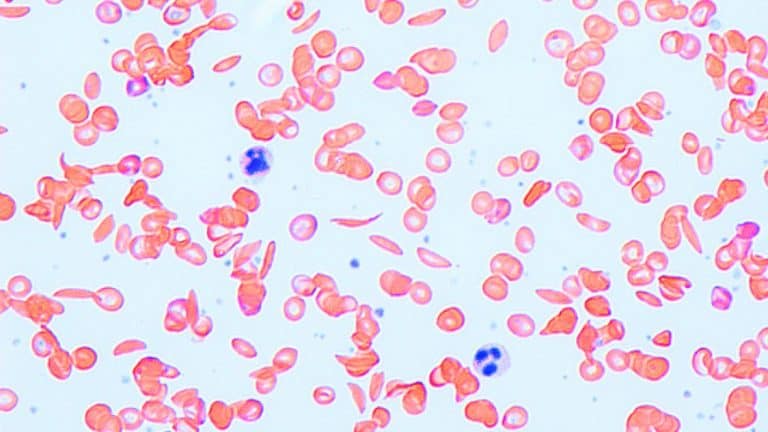

ينجم فقر الدم المنجلي عن خطأ في حرف واحد في جين الهيموجلوبين. ولكن لا يعاني كل من يرث ذلك الخطأ من أسوأ تأثيرات هذا المرض الدموي.
اكتشف العلماء السبب بحلول عام 2008، وهو أن بعض الأشخاص لديهم ميزة جينية ثانية تجعل أجسامهم تستمر في إنتاج الهيموغلوبين الجنيني، وهي وجود نمط من هذه المادة التي تحمل الأوكسجين، والذي لا يتم إنتاجه في الحالة الطبيعية إلا قبل الولادة.
ويقوم التغيّر الجيني الثاني بدور عامل معدِّل، بحيث يكون تأثيره بمثابة مضاد جيني للمرض. والآن، تمكنت شركة ناشئة تدعى ميز ثيرابيوتكس (Maze Therapeutics) من جمع مبلغ مذهل (191 مليون دولار من المستثمرين بمن فيهم ثيرد روك فينتشرز Third Rock Ventures وإيه آر سي إتش فينتشر بارتنرز ARCH Venture Partners وغيرهم) للقيام بالبحث عن هذا العوامل المعدِّلة وإعداد أدوية تحاكي تأثيراتها.
وتخطط الشركة الناشئة -التي تقول بأنها تريد معرفة سبب إصابة بعض الأشخاص بالمرض وعدم إصابة البعض الآخر- للبحث في قواعد البيانات الجينية العامة لتحديد الأشخاص الذين يعانون من أخطاء جينية ولم يواجهوا مشاكل طبية خطيرة.
ويعدّ البحث عن مثل هذه الشذوذات الجينية أحد أحدث المستجدات في مجال تطوير الأدوية. فقد حظي الأمر بالاهتمام عام 2016 بعد ما ذكر المشروع الذي يطلق عليه اسم "مشروع الرجوعية" بأنه وجد 13 شخصاً كان ينبغي أن يصابوا بأمراض خطيرة في مرحلة الطفولة، ولكنهم لم يتعرضوا لذلك. كما راهنت شركات أخرى -بما فيها شركة ريجينيرون (Regeneron) الدوائية- على مستقبلها من خلال جمع مجموعات خاصة من بيانات الحمض النووي والبحث عن الشذوذات.
والجدير بالذكر أن شركة ميز تقول بأنها لا تحتاج إلى إنشاء قاعدة بيانات جينية خاصة بها، والتي تعتبر مهمة مكلفة. وبدلاً من ذلك، ستستخدم المصادر المجانية العامة، بما فيها البنك الحيوي البريطاني الذي يضم جينات وسجلات طبية لـ 500 ألف شخص. ويمكن أن تتوافر بيانات مماثلة قريباً من وزارة شؤون المحاربين القدامى في الولايات المتحدة. ويعدّ مارك دالي من بين مؤسسي الشركة، والذي يشرف على أحد المعاهد الوراثية في فنلندا، والتي تقوم ببناء بنكها الحيوي الخاص بها.
ويقول تشارلز هومسي -الرئيس التنفيذي لشركة ميز: "هناك كم كبير من البيانات الجينية الآن. ولكن قبل خمس سنوات، كان من الخطأ محاولة القيام بهذا الأمر."
كما توجد أدوات جديدة أيضاً للبحث عن العوامل المعدِّلة في المختبر. إذ يقول جوناثان وايسمان -أحد المؤسسين العلميين الآخرين للشركة والباحث في جامعة كاليفورنيا في سان فرانسيسكو- بأنه من الممكن أخذ آلاف الخلايا البشرية المصابة بإحدى الطفرات (مثل الطفرة المسببة لفقر الدم المنجلي)، وإدخال تعديل جيني مختلف في كل منها باستخدام أداة كريسبر لتعديل الجينات.
بعد ذلك، يمكن للباحثين استخدام تقنيات جديدة لاختبار تلك الخلايا المفردة لمعرفة فيما إذا كان أي تعديل من التعديلات يعاكس المرض. ويقول وايسمان: "إنك تأخذ خلية تحتوي على جين يسبب المرض، ثم ترى فيما إذا كان بإمكانك إعادته إلى الوضع الطبيعي. يمكننا إجراء 100 ألف تجربة في وقت واحد، لأن كل خلية هي عبارة عن تجربة خاصة بحدّ ذاتها".
وهناك بالفعل أمثلة عن أدوية تعتمد على اكتشاف الجينات المعدّلة. حيث نجح دواء يُدعى سبينرازا (Spinraza) في علاج ضمور العضلات في العمود الفقري، وهو مرض يحدث في مرحلة الطفولة وغالباً ما يكون مميتاً.